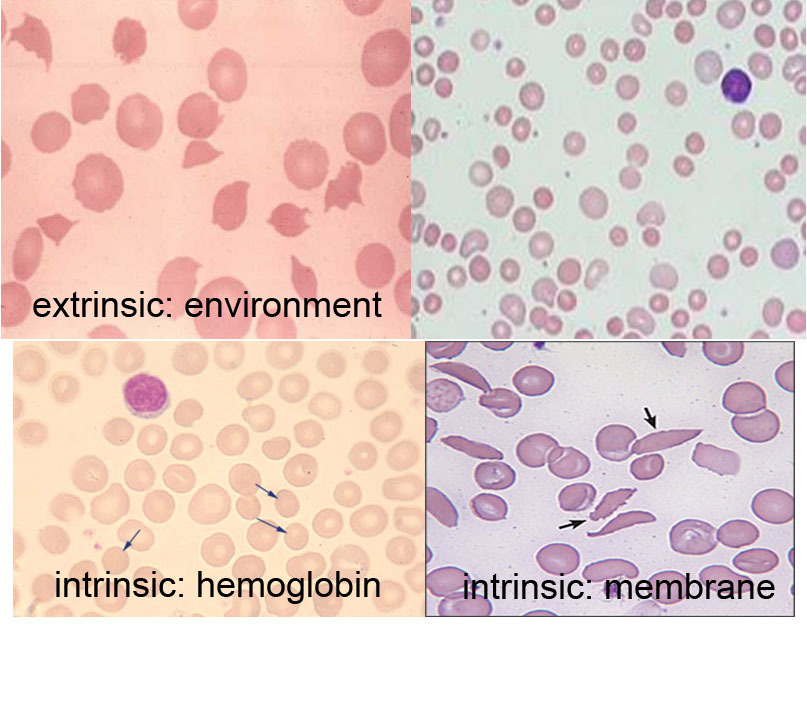

Definition of anemia
Reduction in the total red cell mass
Lower hemoglobin is indicator of anemia, but it is a surrogate value. In pregnancy, the cells are larger but the % of hemoglobin in cells is lower. There is no anemia.
Cell counts are dependent on sex, race, age, and ect.
What % of normal people will be defined anemic?
2.5% because of 2 SD
Why males have higher hemoglobin contect?
Not before puberty. “We all are born females.”
After puberty, it is due to androgens.
How anemia can be classified in 3 categories?
Production
Destruction
Blood Loss
How to distinguish between anemia due to production disorders and anemia due to destruction disorders?
Reticulocytes count
What is a difference between differential diagnosis and
differential diagnosis = diagnostic method used to identify the presence of an entity where multiple alternatives are possible
etiology = cause of the disease
Blood disorder hints
Skin, Facies (facial expressions), Sclera, Mucous membranes, Skeletal/Muscular, Lymph nodes, Liver/Spleen, Nails
Is pale skin a symptom of anemia?
Not necessarily. It is usally a sign of vasoconstriction.
Production disorders
Ineffective? Failure?
Folate deficiency = iron absorption deficiency
Destruction disorders
Extrinsic
Intrinsic
Which variables on the blood tests are directly measured and not calculated?
Hemoglobin content
Blood counts
MCV
Possible blood tests to study anemia
Hemoglobin
MCV
RDW
Reticulocyte
Peripheral smear
Coombs (antibody)
Hemoglobin electrophoresis (hemoglobin sturcture)
Enzymes
Ferroportin
Transports iron across cell membrane (in->out)
Found in intestinal
Ferritin
It is a ubiquitous intracellular protein that stores iron and releases it in a controlled fashion.
How chronic diseases may affect level of iron?
IL6 -> hepcidin (negative iron regulator) -> decreases iron absorption from intestine & decreases release from stores
IL6 -> Binds to and degrades ferroportin
Alpha-thalassemia (HbH)
Involve genes HBA1 and HBA2 that encode alpha chain of hemoglobin leading to excess of beta chain.
Fetal hemoglobin
Alpha2Gamma2
Adult hemoglobin
Alpha2Beta2
Hemoglobin chains over time

Changes in bilirubin levels and associated diseases

Ecchymosis
A discoloration of the skin resulting from bleeding underneath, typically caused by bruising.
Pallorous
Pale appearance
Abnormal findings in patient?
WEEK4
Hepatosplenomegaly
Holosystolic murmur
Hyperdynamic precordium
Hypertensive
Low weight
Laboratory abonrmalities and reflection of them on physical
WEEK4 CASE
Low hemoglobin - pale mucus
MCV low (microcytic anemia) - tiredness
Bilirubin concentration - jaundice